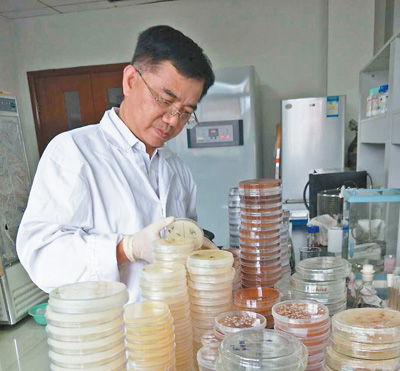

| 分享到: | 更多 |
图为吴庆龙在实验室中分离湖水中的微生物。
小小的微生物,对湖泊有何影响?很多人并不知晓。
我国多样化的湖泊环境,孕育了丰富的微生物资源,揭示微生物如何驱动湖泊生态系统运行,不仅有助于深入了解湖泊生态系统,也为湖泊治理与保护提供了科技支撑。而这,便是中科院南京地理与湖泊研究所研究员吴庆龙30年来醉心研究的领域。
30年来,他穿梭在实验室和湖泊间,从长江中下游平原到雪域高原,在全国22个省份、200多个代表性湖泊留下了科研足迹。
从湖泊资源开发利用转向研究湖泊生态保护,探索微生物的奥秘
“有句话叫做‘流水不腐,户枢不蠹’。前半句是说流动的水体中,微生物可以持续不断地分解污染物质,净化水质。这也从另一个视角告诉我们,湖泊生态治理特别是湖泊微生物学的研究和应用,是一件十分重要且紧迫的课题。”吴庆龙说。
幽静的院落,只闻蝉鸣声声。30年前的一个夏日,不到20岁的吴庆龙第一次踏进中科院南京地理与湖泊研究所,水产养殖专业的他,成为一名技术辅助工作人员。
“我国湖泊科学研究起于上世纪五六十年代,那时进行了一些基础性的湖泊资源调查。后来,随着人们对生物资源、蛋白质资源的需求日益增加,地湖所的科学家们也投入到经济建设的主战场,利用湖泊这个‘水下牧场’开展水产养殖。”吴庆龙说,很快,养殖产量有了提升。
然而,“当初的东太湖清澈干净,水草茂盛。但投放的饲料等不能被鱼类完全利用,加上鱼类排泄物以及鱼类活动等,都对湖泊生态系统产生了负面影响,湖泊水质开始下降。”吴庆龙说。上世纪80年代后期,湖泊水体污染、富营养化等问题在全国范围均有显现。此时的吴庆龙,心中冒出了要重视湖泊生态保护、治理的想法。
1993年,吴庆龙来到南京大学环境科学学院深造,攻读环境生物学硕士学位。3年后他重返所里时发现,大时代正引领着学科研究从湖泊资源的开发利用向湖泊生态保护转型。
“上世纪90年代,我主要研究利用生物指标来显示湖泊环境的变化,从而为湖泊生态环境质量评估和保护提供科学依据。在研究中,我们逐渐认识到,微生物是驱动湖泊生态系统运行的关键,也是污染物质分解与转化的主要推动者。但微生物具体是怎样驱动、分解、转化的,我们并不清楚。”吴庆龙告诉记者,当时在国外,湖泊微生物研究已是湖泊学的重要基础研究部分。1999年,赴奥地利科学院的学习进修经历,更坚定了他转向微生物研究的决心。





京公网安备 11010102002957号